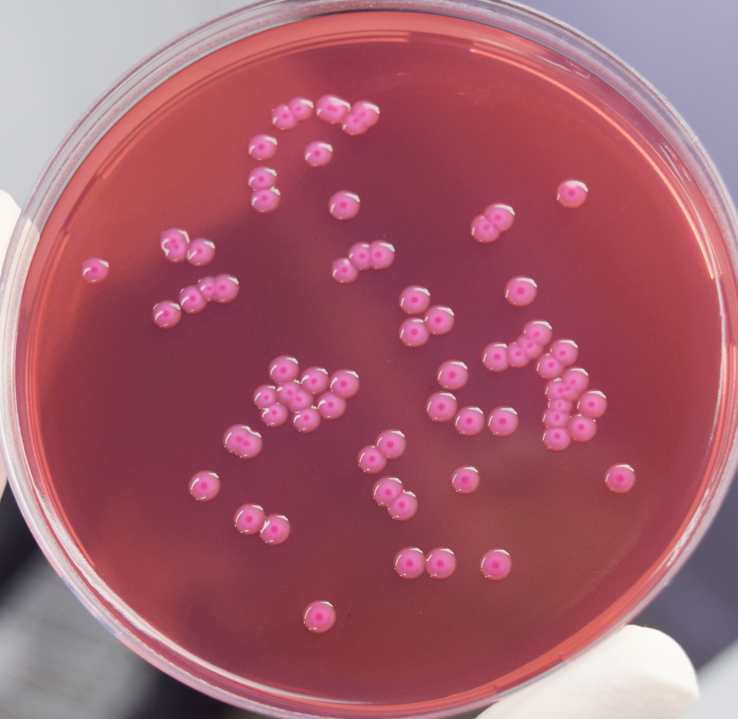
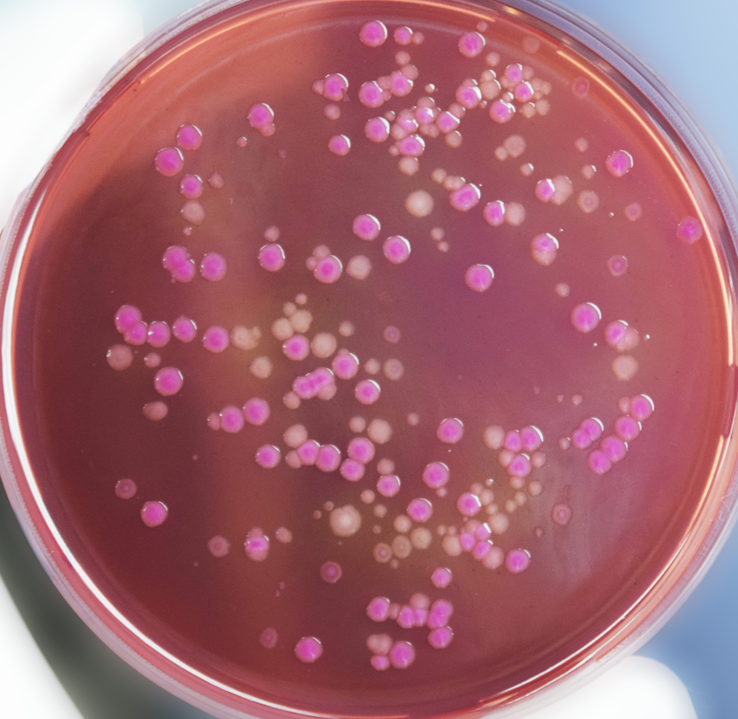
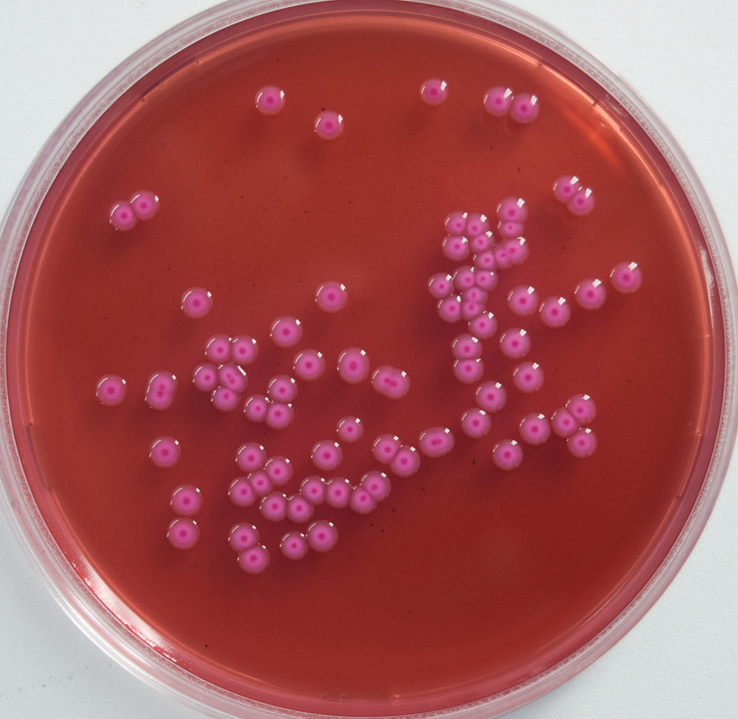

Клебсиеллы в мокроте
Клебсиеллы в мокроте 109 фото
Штучка шипучка
Запаять радиатор уаз
Венгер лабиринты
Жировой гепатоз печени лечение что это
Новый технологий печь
Курск суджа на данный момент
Снять квартиру в воронеже студенту на длительный
Что то во плоти
Дорама бездна желания
Круг на руке что это